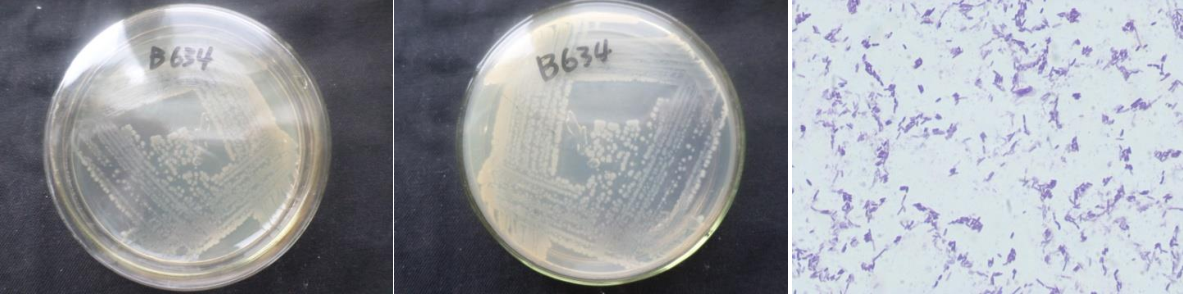

Loading...
| StrainNO | B634 |
| Classification | Bacillus |
| 16s rDNA sequence | TGCTAATACATGCAAGTCGAGCGGACGGATGGGAGCTTGCTCCCTGATGTCAGCGGCGGACGGGTGAGTAACACGTGGGCAACC TGCCTGTAAGACTGGGATAACTTCGGGAAACCGGAGCTAATACCGGATAATTCTTTCCCTCACATGAGGGAAAGCTGAAAGATG GTTTCGGCTATCACTTACAGATGGGCCCGCGGCGCATTAGCTAGTTGGTGAGGTAACGGCTCACCAAGGCAACGATGCGTAGCC GACCTGAGAGGGTGATCGGCCACACTGGGACTGAGACACGGCCCAGACTCCTACGGGAGGCAGCAGTAGGGAATCTTCCGCAAT GGACGAAAGTCTGACGGAGCAACGCCGCGTGAGTGATGAAGGTTTTCGGATCGTAAAACTCTGTTGTTAGGGAAGAACAAGTAC CGGAGTAACTGCCGGTACCTTGACGGTACCTAACCAGAAAGCCACGGCTAACTACGTGCCAGCAGCCGCGGTAATACGTAGGTG GCAAGCGTTGTCCGGAATTATTGGGCGTAAAGCGCGCGCAGGCGGTTCCTTAAGTCTGATGTGAAAGCCCACGGCTCAACCGTG GAGGGTCATTGGAAACTGGGGAACTTGAGTGCAGAAGAGAAGAGTGGAATTCCACGTGTAGCGGTGAAATGCGTAGAGATGTGG AGGAACACCAGTGGCGAAGGCGACTCTTTGGTCTGTAACTGACGCTGAGGCGCGAAAGCGTGGGGAGCAAACAGGATTAGATAC CCTGGTAGTCCACGCCGTAAACGATGAGTGCTAAGTGTTAGAGGGTTTCCGCCCTTTAGTGCTGCAGCAAACGCATTAAGCACT CCGCCTGGGGAGTACGGCCGCAAGGCTGAAACTCAAAGGAATTGACGGGGGCCCGCACAAGCGGTGGAGCATGTGGTTTAATTC GAAGCAACGCGAAGAACCTTACCAGGTCTTGACATCTCCTGACAACCCTAGAGATAGGGCGTTCCCCTTCGGGGGACAGGATGACAGGTGGTGCATGGTTGTCGTCAGCTCGTGTCGTGAGATGTTGGGTTAAGTCCCGCAACGAGCGCAACCCTTGATCTTAGTTGC CAGCATTCAGTTGGGCACTCTAAGGTGACTGCCGGTGACAAACCGGAGGAAGGTGGGGATGACGTCAAATCATCATGCCCCTTA TGACCTGGGCTACACACGTGCTACAATGGATGGTACAAAGGGCTGCGAGACCGCGAGGTTAAGCGAATCCCATAAAACCATTCT CAGTTCGGATTGCAGGCTGCAACTCGCCTGCATGAAGCCGGAATCGCTAGTAATCGCGGATCAGCATGCCGCGGTGAATACGTT CCCGGGCCTTGTACACACCGCCCGTCACACCACGAGAGTTTGTAACACCCGAAGTCGGTGGGGTAACCTTTTGGAGCCAGCCGC CTAAG |
| Strain Morphology Photos | |
| Morphological Description | round;clam white;edge serrated;edge bumps;middle flat;multi-fold;slippy;sticky;waxy;Rod;having spore;bias in budding spores |